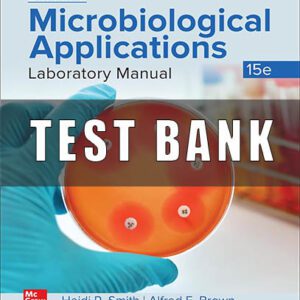

TEST BANKS
Showing 97–108 of 988 results
-
TEST BANKS
Test Bank for Basic Geriatric Nursing 7th Edition
Original price was: $40.00.$30.00Current price is: $30.00. -
TEST BANKS
Test Bank For Basic Geriatric Nursing 8th Edition Patricia A. Williams
Original price was: $50.00.$30.00Current price is: $30.00. -
TEST BANKS
Test bank for Basic Nursing Thinking Doing and Caring 2nd Edition Treas
Original price was: $40.00.$30.00Current price is: $30.00. -
TEST BANKS
Test Bank for Bates Nursing Guide To Physical Examination And History 3rd Edition
Original price was: $50.00.$25.00Current price is: $25.00. -
TEST BANKS
Test Bank for Beckers World of the Cell, 10th Edition Hardin
Original price was: $50.00.$38.00Current price is: $38.00. -
TEST BANKS
Test Bank for Beckmann and Ling’s Obstetrics and Gynecology 8th Edition
Original price was: $35.00.$19.00Current price is: $19.00. -
TEST BANKS
Test Bank for Beckmann and Ling’s Obstetrics and Gynecology 9th Edition
Original price was: $45.00.$22.00Current price is: $22.00. -
TEST BANKS
Test Bank for Behavior Analysis and Learning A Biobehavioral Approach, 6th Edition, W. David Pierce, Carl D. Cheney
Original price was: $50.00.$38.00Current price is: $38.00. -
TEST BANKS
Test Bank for Behavior Analysis and Learning A Biobehavioral Approach, 7th Edition, W. David Pierce, Carl D. Cheney
Original price was: $46.00.$24.00Current price is: $24.00. -
TEST BANKS
Test Bank for Benson’s Microbiological Applications 15th Edition
Original price was: $50.00.$45.00Current price is: $45.00. -
TEST BANKS
Test Bank for Biochemistry 10th Edition by Lubert Stryer, Jeremy Berg, John Tymoczko Gregory Gatto
Original price was: $46.00.$24.00Current price is: $24.00. -
TEST BANKS
Test Bank for Biochemistry 1st Edition Miesfeld
Original price was: $50.00.$35.00Current price is: $35.00.